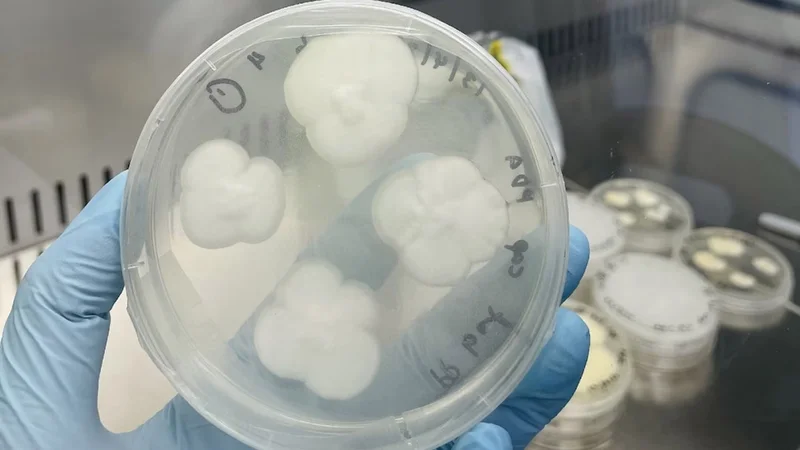
Hongos - Hongos

Un equipo de científicos en Australia ha descubierto dos hongos comunes del suelo capaces de descomponer uno de los plásticos más persistentes del planeta: el polipropileno. En condiciones de laboratorio, Aspergillus terreus y Engyodontium album lograron degradar completamente este material en apenas 140 días. El hallazgo, liderado por la investigadora Amira Farzana Samat en la Universidad de Sídney, abre una vía prometedora hacia soluciones biológicas eficaces frente a la crisis global de residuos plásticos.

Un enemigo resistente: el polipropileno
El polipropileno representa cerca de un tercio de los residuos plásticos del mundo. Se encuentra en objetos cotidianos como tapas de botellas, envases alimentarios y textiles, y puede tardar siglos en descomponerse de forma natural. Esta durabilidad lo hace ideal para múltiples usos industriales, pero también lo convierte en un serio problema ambiental.
La mayoría de estos residuos terminan en vertederos o son incinerados, ya que su reciclaje resulta técnicamente complejo y poco rentable. La diversidad de plásticos y su mezcla con otros materiales complican aún más su procesamiento. Por eso, encontrar una vía eficiente, escalable y ecológica para tratar el polipropileno es uno de los grandes desafíos de la economía circular.
El poder fúngico
Los hongos descubiertos por el equipo australiano no son exóticos ni modificados genéticamente: se encuentran de forma natural en suelos. En condiciones controladas, estos microorganismos degradaron entre el 25 y el 27 % del polipropileno en apenas 90 días, y lo descompusieron por completo al cabo de 140 días.
Para activar el proceso, los investigadores aplicaron un pretratamiento al plástico mediante luz UV, calor o reactivos químicos, debilitando su estructura y facilitando el trabajo de las enzimas de los hongos. Este paso simula las condiciones naturales que permitirían a los hongos adherirse y comenzar la descomposición.
Aunque aún no se entiende del todo el mecanismo exacto de digestión, se sabe que los hongos fragmentan los polímeros en moléculas más simples que luego absorben o eliminan.

Potencial práctico y límites actuales del método
Según el ingeniero químico Ali Abbas, coautor del estudio, este método ofrece la tasa de degradación de polipropileno más rápida registrada hasta ahora en la literatura científica. Sin embargo, todavía hay pasos importantes antes de implementarlo a escala industrial.
El equipo planea construir un prototipo de laboratorio, optimizar los parámetros del proceso y analizar su viabilidad económica y ambiental. Entre los desafíos por resolver están la degradación de plásticos más cristalinos (como los usados en productos comerciales) y la necesidad de reducir los costos del pretratamiento del plástico.
Aun así, el descubrimiento se suma a una creciente ola de innovación en biotecnología ambiental: desde bacterias que descomponen PET en 16 horas, hasta hongos capaces de convertir residuos en biomasa comestible o tecnologías para fabricar bioplásticos desde el aire.
El rol de la biotecnología en la era del plástico
El hallazgo no es una solución mágica, pero sí una pieza clave en el rompecabezas del reciclaje moderno. Apostar por tecnologías disruptivas basadas en procesos biológicos —como el uso de hongos— puede mejorar la circularidad de los plásticos y reducir nuestra dependencia del petróleo.
La velocidad y eficiencia de estas nuevas herramientas, aunque prometedoras, deben ser complementadas con políticas activas de reducción de residuos, rediseño de materiales, educación ambiental, entre otros. Mientras tanto, los hongos del jardín nos recuerdan que algunas de las soluciones más potentes pueden estar justo bajo nuestros pies.
- Biodeterioration of pre-treated polypropylene by Aspergillus terreus and Engyodontium album. Link.
Relacionado
Descubre más desde Cerebro Digital
Suscríbete y recibe las últimas entradas en tu correo electrónico.








